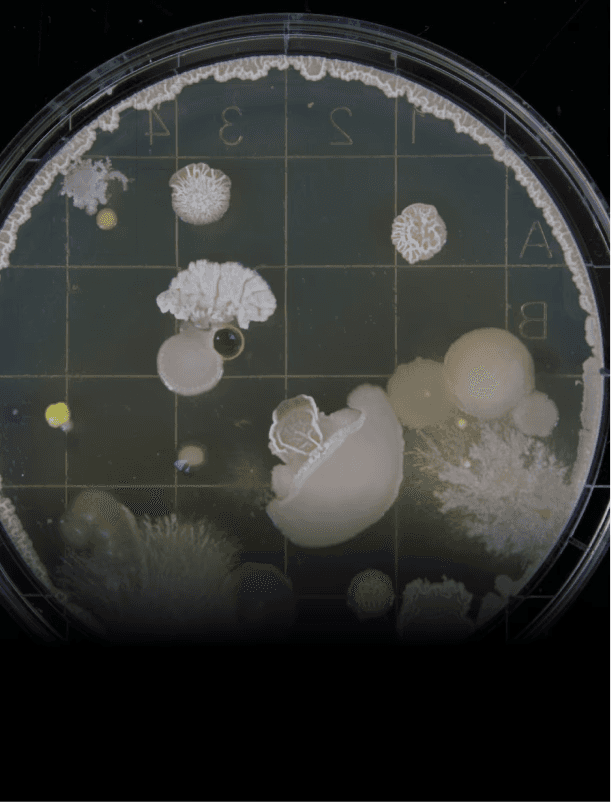

Your emissions are a feedstock
you're not using yet.
Your emissions are a feedstock
you're not using yet.
PhaseBioLabs converts CO₂ directly into chemicals and e-fuels, using fermentation. A bolt-on system for your existing plant.
PhaseBioLabs converts CO₂ directly into chemicals and e-fuels, using fermentation. A bolt-on system for your existing plant.
See how it works
Backed by
Industrial CO₂ is one of the largest untapped feedstocks on earth.
Industrial CO₂ is one of the largest untapped feedstocks on earth.
Direct fermentation
Direct fermentation
Bolt-on installation
Bolt-on installation
Proven outputs
Proven outputs
Built for the bottom line
Built for the bottom line
Heavy industry produces billions of tonnes of it every year. Almost none of it gets used. PhaseBioLabs is changing that, starting with the plants that produce the most
Heavy industry produces billions of tonnes of it every year. Almost none of it gets used. PhaseBioLabs is changing that, starting with the plants that produce the most

Direct CO₂ fermentation
Our proprietary microorganisms consume CO₂ as a direct feedstock, no reforming step, no intermediate processing.

Direct CO₂ fermentation
Our proprietary microorganisms consume CO₂ as a direct feedstock, no reforming step, no intermediate processing.

Bolt-on, not built-in
Designed to integrate with existing plant infrastructure without operational shutdowns or major capital investment.
Bolt-on, not built-in
Designed to integrate with existing plant infrastructure without operational shutdowns or major capital investment.

Waste in. Product out.
CO₂ enters. High-value chemicals and e-fuels come out. What you currently report as an emissions becomes a product you can sell.

Waste in. Product out.
CO₂ enters. High-value chemicals and e-fuels come out. What you currently report as an emissions becomes a product you can sell.
Everyone else converts CO₂. We're the only ones who use it directly.
PhaseBiolabs eliminates that step entirely. Our synthetic biology platform is engineered specifically for direct CO₂ fermentation, which means your feedstock is the cheapest thing in your plant: the gas you were going to vent anyway.

Direct CO2 Utilization

Proven results

Cost efficiency
Everyone else converts CO₂. We're the only ones who use it directly.
PhaseBiolabs eliminates that step entirely. Our synthetic biology platform is engineered specifically for direct CO₂ fermentation, which means your feedstock is the cheapest thing in your plant: the gas you were going to vent anyway.

Direct CO2 Utilization

Proven results

Cost efficiency
Our mission to upcycle 1 Gigaton of CO2 by 2050
Our mission to upcycle 1 Gigaton of CO2 by 2050
We are engineering a sustainable future by upcycling 1 gigaton of CO2 into valuable assets by 2050. Using proprietary synthetic biology, we transform industrial emissions into the building blocks of a circular economy.
We are engineering a sustainable future by upcycling 1 gigaton of CO2 into valuable assets by 2050. Using proprietary synthetic biology, we transform industrial emissions into the building blocks of a circular economy.
About us

Find out what your CO₂ is actually worth.
We work with industrial operators at the feasibility stage to model the revenue potential of their emissions profile.
Learn more
Contact
Companies House Registration No. 12602104 (UK)

Find out what your CO₂ is actually worth.
We work with industrial operators at the feasibility stage to model the revenue potential of their emissions profile.
Learn more
Contact
Companies House Registration No. 12602104 (UK)

Find out what your CO₂ is actually worth.
We work with industrial operators at the feasibility stage to model the revenue potential of their emissions profile.
Learn more
Contact
Companies House Registration No. 12602104 (UK)





